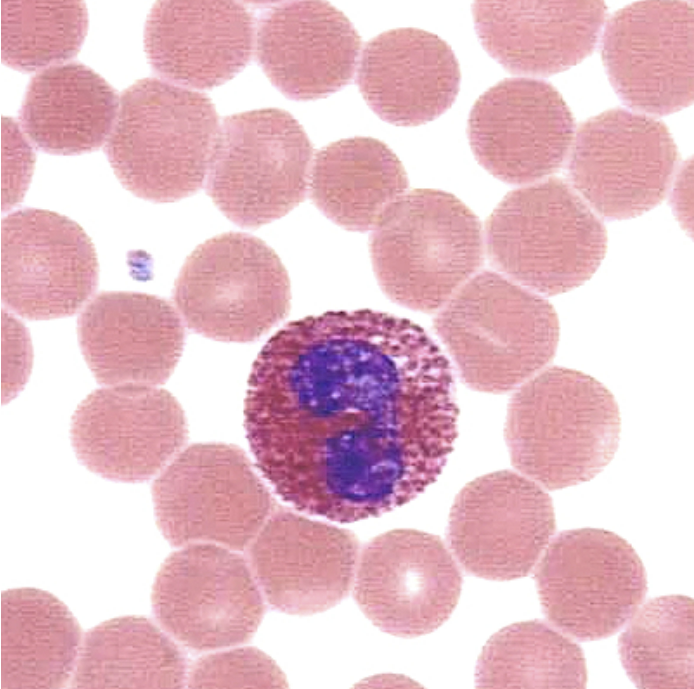

1. 호산구란?
우리의 혈액에는 백혈구, 적혈구, 혈소판이 있습니다. 여기 백혈구에는 호중구, 림프구, 호염기구, 호산구 및 단핵구가 있습니다. 호산구와 호중구는 세균 감염에 대한 방어 및 세균과 싸우는 역할을 하며, 림프구는 면역 반응을 조절하는 역할을 합니다. 단핵구는 세균 감염보다 바이러스 감염에 더 많이 관여합니다. 일반적으로 500 미만이어야 합니다. 여기서 500 이상의 값을 보면 호산구증가증을 의심해볼 수 있습니다.
2. 호산구는 언제 증가합니까?
2-1 기생충 감염
과거 한국의 소득 수준이 높지 않았을 때는 기생충, 특히 장내 기생충 감염(요충, 회충 등)이 흔했습니다. 그러나 소득이 증가함에 따라 요충과 회충보다 더 많은 감염, 게와 민물고기를 먹음으로 인한 간흡충과 폐흡충, 비둘기의 잠복결핵증과 개와 고양이에 의한 톡소플라즈마 기생충이 체내에 많이 발생하고 있기 때문에 수치가 높아집니다. 호산구는 이러한 기생충을 공격하고 파괴하는 역할을 합니다.
2-2 알레르기
일반적으로 생각하는 발진, 알레르기성 비염, 천식, 아토피 등의 질환이 발생하면 호산구 수치가 높아질 수 있습니다.
2-3 약을 먹다
호산구 증가로 인해 가장 흔하게 발생하는 요인 중 하나로, 약물 복용에 의해 호산구 수가 증가하는 경우가 많다. 최근에 새로운 약을 복용하고 혈액 검사를 받은 경우 호산구 수치가 종종 상승합니다.

3. 호산구 증가 증후군
주로 호산구 증가를 일으키는 요인 기생충 감염, 알레르기, 약물 사용과의 접촉점이 없고 이유 없이 호산구가 증가하는 경우를 호산구 증가 증후군으로 분류하고 치료를 시작하는데, 이 경우 대개 골수에서 혈액 생성 다섯 가지 백혈구(호중구, 호염구, 단핵구, 림프구, 호산구)에서 분열하여 호산구를 생산하는 쪽이 생겨서 호산구 수가 급격하게 증가하는 경우입니다.
호산구의 수가 6개월 이상 500개 이상으로 증가하거나 호산구가 장기를 침범하면 확실히 호산구 증후군으로 정의할 수 있습니다. 이러한 것들을 확인하기 위해 다양한 테스트가 수행됩니다. 특히 호산구의 수가 1500개 이상으로 늘어나면 치료를 해야 한다.

4. 검사
4-1 일반혈액검사
백혈구, 적혈구, 혈소판 증가 여부와 백혈구에서 호산구 증가 정도를 확인하기 위해 일반 혈액 검사를 실시합니다.
4-2 말초혈액분포검사
혈액을 슬라이드에 얇게 펴 바른 후 육안으로 호산구가 얼마나 증식했는지, 비정상 세포가 있는지를 확인합니다.
4-3 기생충 검사
호산구 증가로 이어질 수 있는 이차 원인을 확인하기 위해 기생충 검사를 실시합니다.
4-4 IgE 및 알레르기 검사
면역글로불린 E(IgE) 검사는 주로 알레르기 진단에 사용됩니다. 폐기능 검사와 알레르겐 검사를 시행합니다.
4-5 DNA 검사
호산구 수가 증가하면 스테로이드를 사용하여 치료하는데 특별한 유전자 검사를 하고 PDGFR 알파나 베타 유전자 검사에 이상이 있는 경우 이마티맵이라는 치료를 결정한다.
4-6 폐(X선, CT)
폐가 호산구에 의해 침범되었는지 확인하기 위해 X-레이 또는 CT 스캔을 수행하여 진단할 수 있습니다.
4-7 간, 비장(CT, 초음파)
호산구는 또한 간과 비장에 잘 붙습니다. 호산구가 덩어리를 형성하면 장기에 손상을 줄 수 있어 즉각적인 치료가 필요할 수 있어 정확한 진단을 위해 검사를 받는 것이 좋다.
4-8 심초음파
호산구가 심장에 부착되면 덩어리를 형성하면 심장의 기능을 악화시키기 때문에 즉시 치료해야 합니다. B. 심부전.

혈액 검사 결과 호산구 증가증이 나타나면 정확한 진단과 치료 과정을 결정하기 위해 혈액 전문의를 만나는 것이 중요합니다.